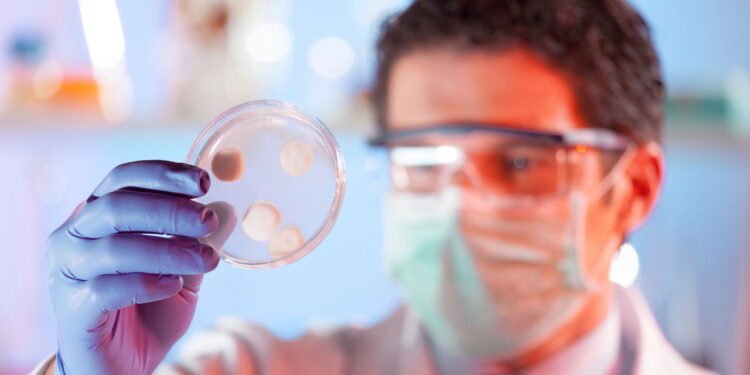
Fungos - Créditos: depositphotos.com / kasto

Os fungos desempenham papéis essenciais no ecossistema da pele humana que vão além da simples presença indesejada nas unhas ou dedos dos pés. Embora o entendimento popular frequentemente associe fungos a infecções como a micose, eles fazem parte de uma comunidade complexa chamada micobioma da pele, que interage com bactérias e com o sistema imunológico, influenciando diretamente a saúde cutânea.
O que é o micobioma cutâneo e quais fungos vivem na pele?
O micobioma cutâneo é o conjunto de fungos que habitam diferentes regiões do corpo humano, especialmente as zonas mais úmidas, como os pés e as áreas de dobras. Esses micro-organismos coexistem com bactérias e formam um ecossistema equilibrado que contribui para a proteção e a integridade da barreira cutânea.
Nessas regiões úmidas, observa-se maior diversidade de espécies, destacando-se os gêneros Malassezia, Aspergillus e Candida. Em condições normais, esses fungos convivem de forma harmônica com o hospedeiro, mas o desequilíbrio pode levar a infecções e outras complicações dermatológicas.
Como os fungos da pele interagem com o sistema imunológico?
Os fungos na superfície da pele mantêm interações ativas com o sistema imunológico e não são apenas organismos passivos. O contato entre as paredes celulares fúngicas e as células de defesa ajuda a manter um estado de vigilância, permitindo respostas rápidas a micróbios potencialmente prejudiciais.
Esse diálogo constante é fundamental para “treinar” o sistema imunológico a responder de forma adequada. Um micobioma equilibrado favorece respostas imunológicas mais eficientes, reduzindo a chance de reações inflamatórias exageradas que podem aparecer como dermatites ou outras doenças de pele.

Quais são os riscos do uso indiscriminado de antifúngicos?
O uso frequente e desinformado de antifúngicos sem supervisão médica pode causar efeitos adversos importantes. Ao eliminar fungos benéficos, esses medicamentos podem desorganizar o micobioma da pele, enfraquecer sua proteção natural e favorecer o surgimento de cepas resistentes, dificultando tratamentos futuros.
Algumas consequências comuns do uso inadequado de antifúngicos na pele incluem:
🧬💙 Impactos do Desequilíbrio no Micobioma
| Fator | Descrição |
|---|---|
| Desequilíbrio do ecossistema | Alteração da relação entre fungos e bactérias, abrindo espaço para microrganismos oportunistas. |
| Inflamação cutânea | Mudanças no micobioma podem desencadear ou agravar processos inflamatórios. |
💡 Dica: Manter o equilíbrio da microbiota da pele é essencial para prevenir inflamações e problemas dermatológicos.
Como manter o equilíbrio saudável dos fungos na pele?
Manter a integridade do micobioma cutâneo depende de hábitos simples e consistentes de cuidado pessoal. Secar bem os pés após o banho, usar calçados arejados, evitar excesso de umidade e não utilizar medicamentos antifúngicos sem prescrição são medidas eficazes para preservar esse equilíbrio.
Pesquisas em microbiologia vêm demonstrando o papel fundamental dos fungos na estabilidade do ecossistema da pele e no treinamento do sistema imunológico. Por isso, é importante repensar a visão sobre os fungos cutâneos, entendendo-os não apenas como agentes de infecção, mas como componentes vitais de uma comunidade biológica que protege e sustenta a saúde da pele.
Entre em contato: Dra. Anna Luísa Barbosa Fernandes
CRM-GO 33.271
Dra. Anna Luísa Barbosa Fernandes
CRM-GO 33.271